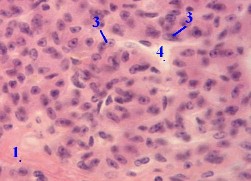

1. а) Выделяют два вида секреторных клеток (3):  главные паратироциты (с базофильной цитоплазмой) и главные паратироциты (с базофильной цитоплазмой) и  оксифильные паратироциты (Иногда говорят также о переходных паратироцитах.) б) Несмотря на различие в тинкториальных свойствах, на препарате эти клетки обычно трудно различимы. 2. Кроме паратироцитов (3), на приведённом снимке видны также оксифильные паратироциты (Иногда говорят также о переходных паратироцитах.) б) Несмотря на различие в тинкториальных свойствах, на препарате эти клетки обычно трудно различимы. 2. Кроме паратироцитов (3), на приведённом снимке видны также  прослойки рыхлой соединительной ткани (1) и прослойки рыхлой соединительной ткани (1) и  капилляры (4). капилляры (4). | 4,б. Препарат – паращитовидная железа. Окраска гематоксилин- эозином. (Большое увеличение) Полный размер Полный размер |
II. Главные паратироциты
| Морфо- логия | а) Главные паратироциты - мелкие клетки полигональной формы. б) Из-за их небольших размеров,  ядра соседних клеток лежат близко друг к другу ядра соседних клеток лежат близко друг к другу  и создаётся впечатление очень плотного расположения клеток в железе. в) В свою очередь, главные паратироциты делятся на и создаётся впечатление очень плотного расположения клеток в железе. в) В свою очередь, главные паратироциты делятся на  тёмные – активно функционирующие клетки, и тёмные – активно функционирующие клетки, и  светлые – видимо, неактивные, покоящиеся клетки. светлые – видимо, неактивные, покоящиеся клетки. |
| Функция | а) Именно тёмные главные паратироциты образуют гормон околощитовидных желёз –  паратгормон, повышающий содержание Са2+ в крови. б) Он является полипептидом, поэтому в тёмных клетках – много рибосом (в составе шероховатой ЭПС). в) Отсюда – базофилия их цитоплазмы, сообщающая клеткам тёмный вид. паратгормон, повышающий содержание Са2+ в крови. б) Он является полипептидом, поэтому в тёмных клетках – много рибосом (в составе шероховатой ЭПС). в) Отсюда – базофилия их цитоплазмы, сообщающая клеткам тёмный вид. |
| Тетания | а) При удалении паращитовидных желёз развивается тетания - судорожное состояние, обусловленное резким снижением концентрации в крови ионов Са2+. б) Механизм тетании связан с тем, что  Са2+ уменьшает возбудимость мышечных и нервных мембран (блокируя в них ионные каналы), Са2+ уменьшает возбудимость мышечных и нервных мембран (блокируя в них ионные каналы),  отчего при недостатке Са2+ в крови возбудимость возрастает. отчего при недостатке Са2+ в крови возбудимость возрастает. |
III. Оксифильные паратироциты
| Морфо- логия | а) Эти клетки по размеру крупней, чем главные клетки, а их цитоплазма, как следует из названия, – оксифильная. б) Бoльшую часть объёма клеток занимают крупные митохондрии, расположенные порой очень плотно |
| Накопление с возрастом | С возрастом количество оксифильных паратироцитов в околощитовидных железах увеличивается. |
| Природа клеток | а) Функция оксифильных паратироцитов (так же, как функция оксифильных клеток Ашкенази в щитовидной железе) не ясна. б) Есть мнение, что и те, и другие клетки являются продуктом дегенерации основных гормонпродуцирующих клеток. в) Но этому противоречит высокая активность в оксифильных клетках митохондриальных ферментов. |

 2015-01-07
2015-01-07 3678
3678








